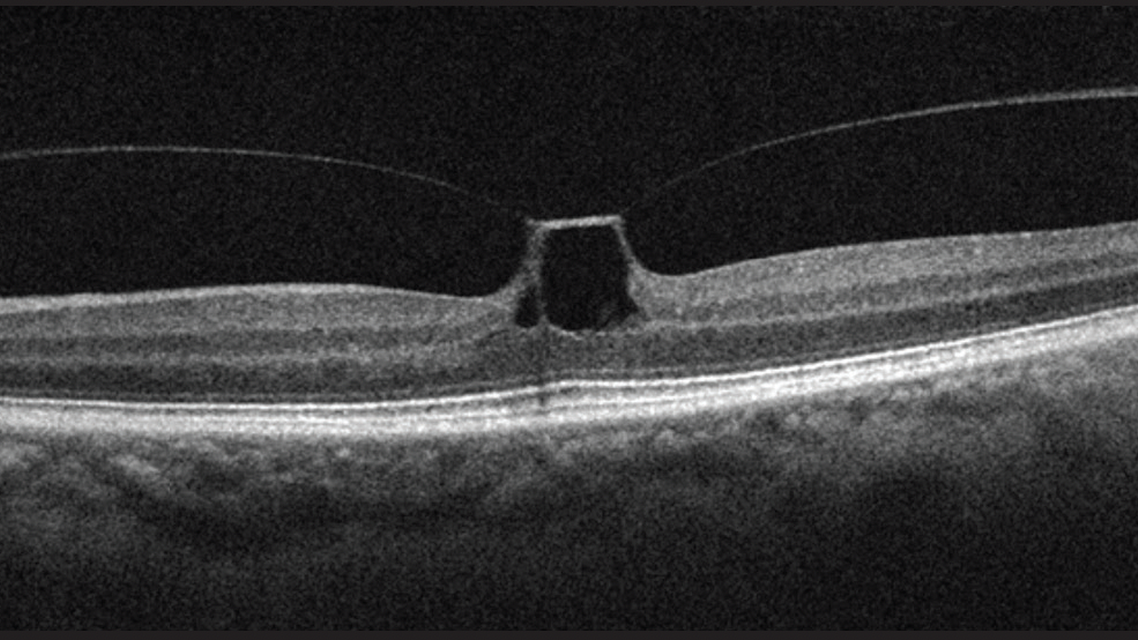
Putting the V in Vitreomacular Traction

Putting the “V” in Vitreomacular Traction
Vitreomacular traction (VMT) is characterized by abnormal attachment of the posterior cortical vitreous to the macula, which often leads to macular distortion and visual disturbances such as reduced acuity and metamorphopsia. VMT incidence is 65% higher in women than in men, likely due to premature vitreous liquefaction associated with declining postmenopausal estrogen levels.1
MANAGING VMT
Recent studies have uncovered that a significant percentage (11-53%) of VMT cases resolve on their own without the need for surgical intervention.1-3 Tzu et al2 and John et al3 reported that 31% to 32% of eyes had spontaneous release of VMT over 1 year; by the last follow-up visit, pars plana vitrectomy (PPV) was performed in fewer than 5% of eyes in each study.
Factors influencing the likelihood of spontaneous resolution include a better presenting visual acuity, smaller vitreomacular attachment areas, and a V-shaped vitreous attachment (ie, a posterior hyaloid detached both nasally and temporally with respect to the fovea and attached only to the fovea; Figure).1

Conversely, cases associated with more extensive vitreomacular adhesion (>1500 μm) or other complicating factors, such as epiretinal membrane formation or diabetic macular edema, are less likely to resolve spontaneously.1 In addition, patients with macular holes, significant macular edema, persistent metamorphopsia, and/or reduced visual acuity despite monitoring may be more likely to require surgical intervention.1
Surgical options include enzymatic vitreolysis, pneumatic vitreolysis, and PPV. PPV is often considered the treatment option of choice for patients with symptomatic VMT.1 Surgical outcomes are generally favorable, with PPV offering higher efficacy in relieving traction and improving visual function.1
That said, patients with broad or J-shaped VMT (ie, vitreous cortex detached from the temporal retina but attached nasally to the fovea and to the fovea itself) that is associated with significant macular hole formation or epiretinal membrane may have a higher risk of poor anatomic and functional outcomes following surgery.1
Referring to a retina specialist is advisable if you notice signs of complications such as macular holes, persistent edema, or retinal detachment or if the VMT persists and is causing significant visual impairment.1 Early referral can help ensure appropriate management and minimizes the risk of irreversible damage to the retina.
CONSIDER LONG-TERM OUTCOMES
By carefully assessing these factors and including retina specialists when necessary, optometrists can optimize outcomes for patients with VMT and prevent long-term visual complications. The natural course of this condition is known to be variable, and studies have shown that initial observation generally led to favorable outcomes. Where surgery is necessary, PPV is standard.
Ready to Claim Your Credits?
You have attempts to pass this post-test. Take your time and review carefully before submitting.
Good luck!